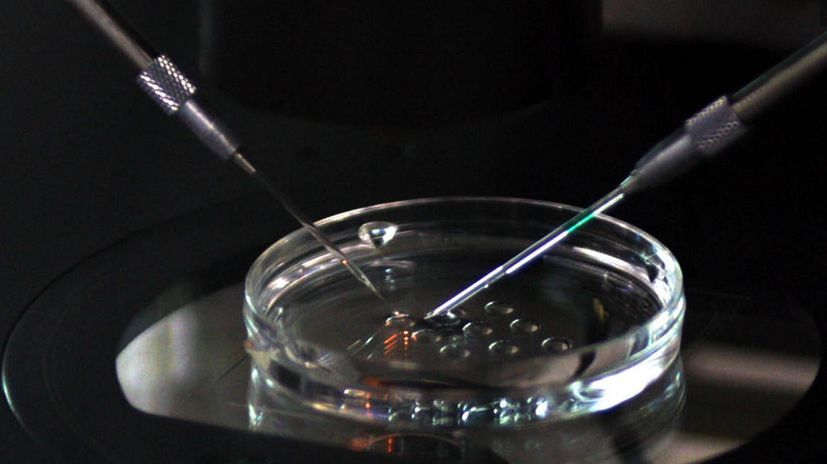
试管婴儿取卵后出现腹胀该怎么办

取卵针图片

取卵针
图片尺寸3133x2110
取卵针
图片尺寸970x1026
取卵针
图片尺寸5497x3087
取卵穿刺针的取卵过程这跟针竟然有那么长
图片尺寸500x1209
全麻取卵针刺01
图片尺寸1080x1440
取卵针这么长
图片尺寸1080x845
取卵针
图片尺寸4624x2822
图文详解取卵针取卵手术全过程4个步骤真没想象中可怕
图片尺寸600x450
pcc取卵器
图片尺寸521x521
取卵针
图片尺寸783x483
好孕时光第五期:mini ivf双腔取卵针技术
图片尺寸400x225
取卵针
图片尺寸478x340
稠密!取卵针是什么"自求多福"-第1张图片-万宝网
图片尺寸4528x3094
高清展示试管婴儿取卵过程!尖尖的针看着都疼!
图片尺寸964x602
一次性使用取卵针
图片尺寸1000x1000
试管婴儿取卵后出现腹胀该怎么办
图片尺寸827x464
这根管子学名取卵针,作为取卵手术最重要的工具,针长35厘米,针口直径2
图片尺寸1280x969
花开富贵!取卵过程"日思夜想"-第2张图片-西安论坛资讯
图片尺寸1080x1920
家恩德运做试管婴儿取卵取精注意事项你真的了解吗
图片尺寸800x500
给大家看看取卵针 男人不行就换哈 别让自己遭罪
图片尺寸960x1280